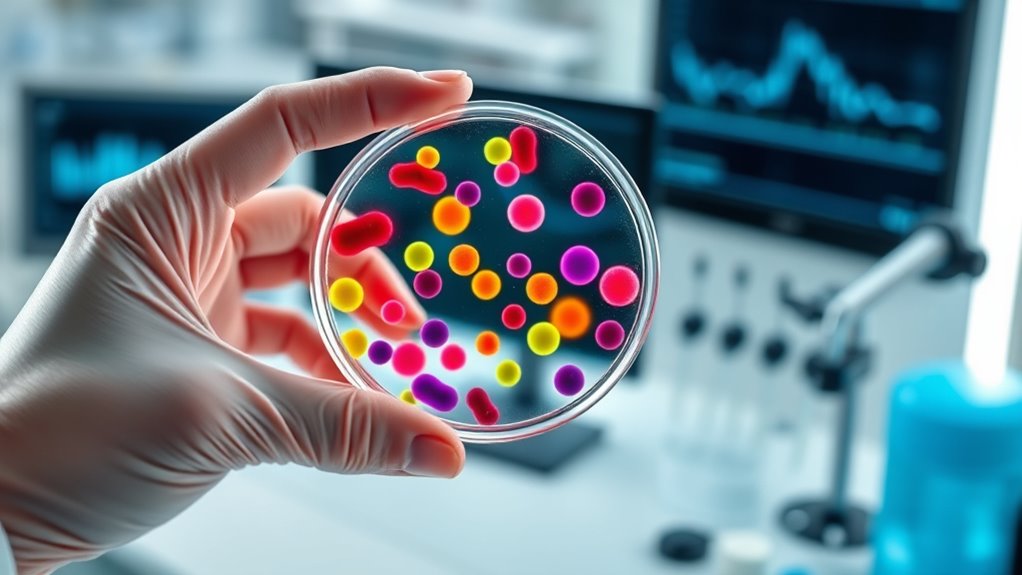
exact test for categorical data

Fisher’s Exact Test helps you analyze the relationship between categorical variables, especially when data is sparse or sample sizes are small. It calculates an exact p value, giving you precise results without relying on large-sample assumptions. If your data has low expected counts or involves rare conditions, this test is ideal. Keep exploring to discover how it works and how to interpret its results for your specific studies.
Key Takeaways
- Fisher’s Exact Test calculates the probability of observed data in a 2×2 table without relying on large-sample assumptions.
- It is ideal for small sample sizes and when some expected counts are low, ensuring accurate p values.
- The test assesses whether there’s a significant association between categorical variables by computing exact probabilities.
- A small p value suggests a potential relationship, while a large p value indicates data is consistent with no association.
- It provides a precise measure of evidence against the null hypothesis, especially useful in sparse or rare data scenarios.

Have you ever wondered how to determine if two categorical variables are related in small sample sizes? When you’re working with limited data, traditional tests like the chi-square can fall short because they rely on large sample assumptions. This is where Fisher’s Exact Test shines. It’s a statistical method designed specifically for small samples, providing an exact p value, which means it calculates the probability of observing your data under the null hypothesis without relying on approximations. This makes it especially useful when your sample size is too small for other tests to be reliable.
Understanding the p value interpretation in Fisher’s Exact Test is essential. The p value represents the probability that the observed data, or something more extreme, would occur if the null hypothesis — that there’s no association between the variables — were true. A small p value, typically less than 0.05, suggests that the observed relationship is unlikely to have occurred by chance alone, leading you to think that the variables may indeed be related. Conversely, a larger p value indicates that your data is consistent with the null hypothesis, and there’s not enough evidence to claim a relationship exists.
A small p value suggests a potential relationship between variables, while a larger one indicates data consistency with no association.
One of the main advantages of Fisher’s Exact Test is that it doesn’t depend on large-sample assumptions. Instead, it directly calculates the probability of your observed contingency table, given the marginal totals. This makes it especially appropriate for small sample sizes where the data are sparse or the expected counts in some cells are low. For instance, if you’re studying rare conditions or limited pilot data, Fisher’s Exact Test provides a precise p value rather than an approximation, giving you more confidence in your results. Additionally, understanding the concept of exact p values can help you appreciate the reliability of the test’s results when dealing with small datasets.
When interpreting the p value from Fisher’s Exact Test, keep in mind that it’s a measure of evidence against the null hypothesis. A low p value points toward a potential association between your categorical variables, but it doesn’t prove causation. Also, it’s important to consider the context of your study and the predefined significance level you’re using. If the p value is below this threshold, you may reject the null hypothesis, but if it’s above, you should refrain from making strong claims about the variables being related.
Fisher's Exact Test calculator
As an affiliate, we earn on qualifying purchases.
As an affiliate, we earn on qualifying purchases.
Frequently Asked Questions
How Does Fisher’s Exact Test Compare to Chi-Square Tests?
You’ll find Fisher’s Exact Test more accurate than chi-square tests when working with small sample sizes because it doesn’t rely on the large sample assumptions that chi-square tests do. Unlike chi-square, which approximates probabilities, Fisher’s calculates exact probabilities, making it ideal for small or sparse data. If your data meets the test assumptions and sample size is limited, Fisher’s provides a more reliable comparison.
Can Fisher’s Exact Test Be Used for Large Sample Sizes?
Like a tiny boat steering a vast ocean, Fisher’s Exact Test struggles with large sample sizes. Its sample size limitations make it impractical for extensive data, prompting you to seek alternative statistical tests like the chi-square test. These alternatives handle larger samples efficiently, ensuring accurate results without the computational burdens Fisher’s test faces. So, when your data grows, switch from Fisher’s to methods better suited for the expansive sea of information.
What Are Common Errors When Interpreting Fisher’s Exact Test Results?
When interpreting Fisher’s Exact Test results, you should watch out for misinterpretation pitfalls like assuming causation from a significant association, which is incorrect. You might also make incorrect assumptions about the data’s independence or sample size. Avoid overgeneralizing findings or ignoring the test’s limitations with small samples. Always consider the context, and remember that a significant result indicates association, not causality, helping you avoid common errors.
Is Fisher’s Exact Test Suitable for Continuous Data?
You shouldn’t use Fisher’s Exact Test for continuous data because it’s designed for categorical variables, not continuous data. This test excels in small sample sizes and 2×2 tables, but it has limitations when applied beyond these. For continuous data, you need tests like t-tests or ANOVA that compare means directly. Relying on Fisher’s for continuous data ignores its test limitations and risks misleading results.
How Do I Perform Fisher’s Exact Test Manually?
To perform Fisher’s Exact Test manually, start by creating a contingency table with your data. Then, calculate probabilities for each possible table by using the hypergeometric distribution, focusing on the observed table. Sum the probabilities of all tables as extreme or more extreme than your observed one. This process involves calculating combinations for each cell, which can be tedious but helps you understand how probabilities are derived in contingency tables.

Oil Analysis Starter Kit Including Test Kits, tubing and Sample Pump
NOT FOR USE ON AIRCRAFT!
As an affiliate, we earn on qualifying purchases.
As an affiliate, we earn on qualifying purchases.
Conclusion
Think of Fisher’s Exact Test as your trusty map in a dense jungle of data. It guides you through the thick foliage, helping you spot true connections amid the chaos. With this test, you’re not wandering aimlessly—you’re confidently steering through toward answers. So, when uncertainty clouds your path, remember, Fisher’s Exact Test is your compass, turning complex data into a clear trail. Trust it, and find your way to meaningful conclusions with ease.
2×2 contingency table analysis tool
As an affiliate, we earn on qualifying purchases.
As an affiliate, we earn on qualifying purchases.

Statistical Process Control for Small batch Production
As an affiliate, we earn on qualifying purchases.
As an affiliate, we earn on qualifying purchases.